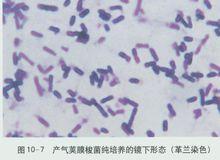
韋氏梭菌

細菌介紹
韋氏梭菌又名產氣莢膜梭菌,由Wellech等1892年首先分離到,當時認為是一種創傷感染病原菌。現已證實它可經消化道對人類產生危害,並可引起大規模食物中毒。韋氏梭菌廣泛分布於人畜糞便、土壤、污水等外環境中,其產生的腸毒素是引起食物中毒的主要因素,被污染的食物即使在烹調加熱後,其芽孢仍可在較高溫度、長時間貯存的過程中生長、繁殖,隨食物進入腸道並產生腸毒素而引起中毒。
韋氏梭菌
韋氏梭菌形態特徵
本菌為革蘭氏陽性厭氧芽抱桿菌,無鞭毛, 不運動,菌體兩端鈍圓、呈粗桿狀,單個、成雙或者成短鏈狀存在,個別菌體有芽孢。菌落呈正圓形,邊緣整齊,表面濕潤、粘稠、光滑隆起,直徑約2 mm,菌落周圍出現雙重溶血環 。
該菌能液化明膠, 不液化凝固蛋白。分解葡萄糖、乳糖、蔗糖、麥芽糖而產酸產氣。不分解甘露醇、阿拉伯糖,不產生靛基質,凝固牛奶而產酸產氣。
危害
韋氏梭菌是一種重要的人獸共患病的病原體,可引起多種動物壞死性腸炎、腸毒血症,同時也是人畜創傷性氣性壞疽以及人類食物中毒的主要病原菌之一。該菌群屬典型的條件致病菌,可以引起地區性流行,也有散發性報導,每年都有大量的動物因不同的產氣莢膜梭菌感染而死亡。
臨床表現
該菌引起食物中毒大多為集體性暴發,潛伏期最短3h,最長50h,多數10~15h;一般發病突然,要以腹瀉、臍周腹痛(部分絞痛)、噁心、嘔吐等急性胃腸炎症狀為主,少數發熱情況。經治療多數在1~3 天內恢復健康,少數需一周才完全康復 。
致病機理
該菌的致病因子是其所產生的外毒素。到目前為止,已發現的外毒素有12種(α, β , γ, δ, ε, η, θ, ι, κ, λ, μ和ν), 但以α, β, ε和ι這4種外毒素最為主要,並可據此將該菌分為A、B、C、D、E 5個毒素型 。產氣莢膜梭菌主要致死性毒素的毒性, 主要取決於毒素質粒的存在和缺失。
α毒素
各型產氣莢膜梭菌均產生α毒素,它是產氣莢膜梭菌最重要的毒素之一,同時又是A 型產氣莢膜梭菌的主要毒素。它具有磷脂酶C (PhospholipaseC, PLC)和鞘磷脂酶(Sphingomyelinase)兩種酶活性,能水解細胞膜的主要成分膜磷脂,從而破壞細胞膜結構的完整性。α毒素引起氣性壞疽的機制,首先是使內皮細胞、血小板和嗜中性粒細胞之間的信號傳導通路發生紊亂,導致某些細胞間介質和粘附分子的異常產生,進而改變嗜中性粒細胞與受感染組織間的聯繫,並促進血栓形成,從而製造一個更有利於厭氧生長的條件,最終引起氣性壞疽 。
β毒素
產氣莢膜梭菌β 毒素是由產氣莢膜梭菌B 型和C 型菌株產生的壞死、致死性毒素,是一種強毒素,具有細胞毒性、致死性,可引起人和動物的壞死性腸炎。β 毒素分為β1、β2毒素, 其中β2毒素是近年確認的由C 型產氣莢膜梭菌產生的一種新的毒素,其機制尚未明確 。
ε毒素
ε毒素是由B型和D型產氣莢膜梭菌所產生,能引起家畜的致死性腸毒血症,又稱肉性腎病。其結構與氣單胞菌溶素很相似,是一種孔形成毒素。
ι毒素
ι毒素僅由E 型產氣莢膜梭菌分泌,是一種由酶部分(Ia)和結合部分(Ib)兩個部分組成的二元毒素。Ia 是一種ADP-核糖轉移酶,分子量約47ku;Ib是一種細胞結合蛋白,分子量約81 ku。Ib低聚體在細胞膜形成後,能誘導細胞內吞作用。
預防
該菌食物中毒主要問題是:溫度掌握不適當;食物來源不安全;燒煮不充分;食物製作者個人衛生不良; 設備受污染等。凡預防一般食物中毒的措施對防制該菌食物型傳播同樣有效。防制的關健是避免該菌污染食品,同時控制它的存在和繁殖,使其在食品中的數量降至最小程度。此外,應做到生熟餐具分開,以防交叉感染;熟肉製品低溫保存,尤其是長時放置的肉類蛋白性食品食前充分加熱,以殺滅殘剩芽胞或生殖型韋氏梭菌;建議在食物鏈形成環節上制訂嚴格的控制程式,以防大規模食物中毒的暴發 。

